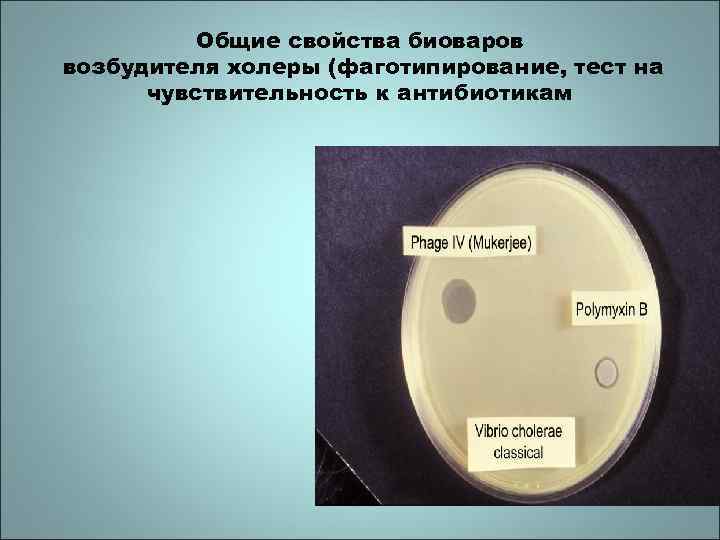
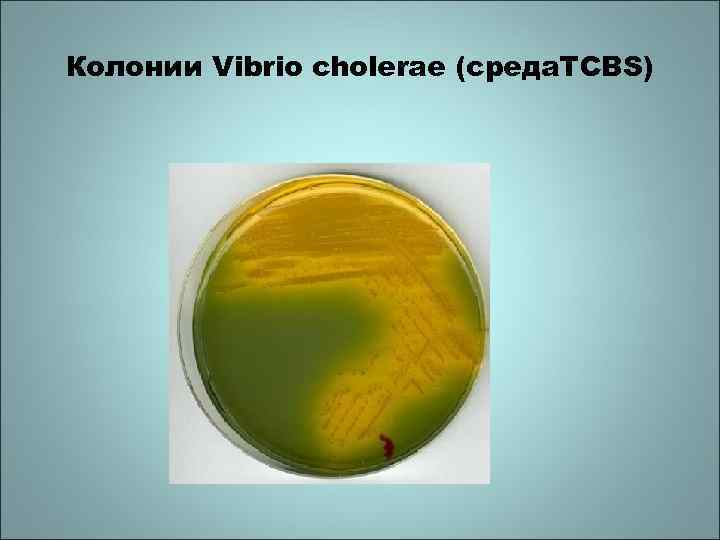
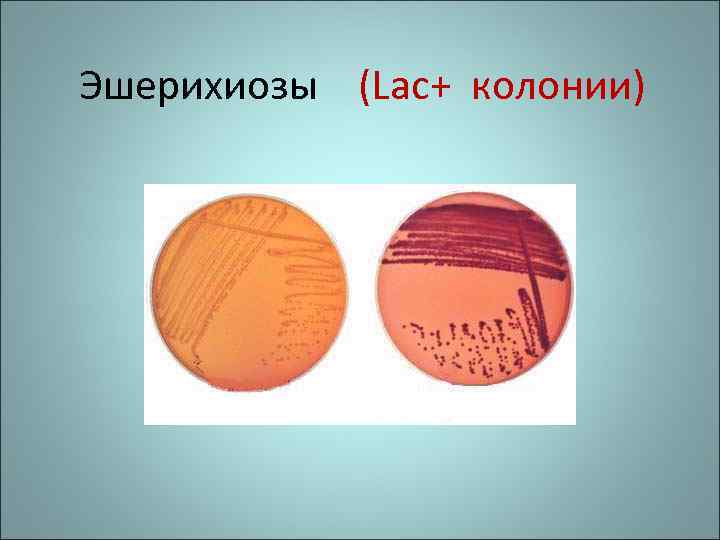
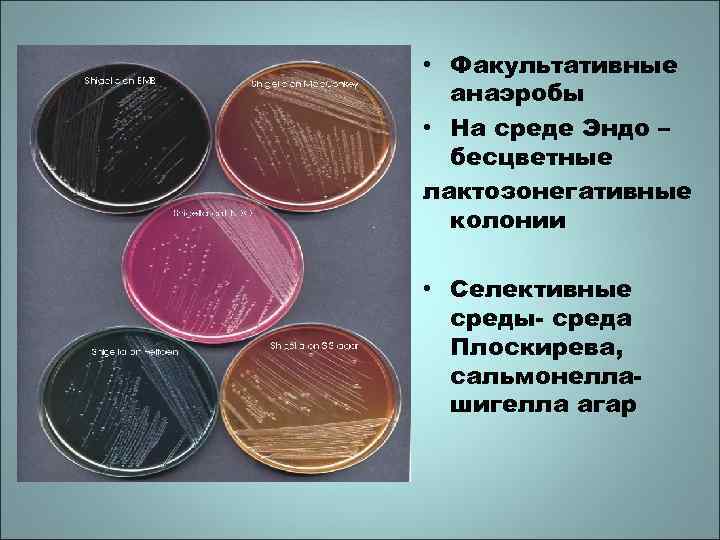

Холера, эшерихиозы, дизентерия, листериоз.ppt
- Количество слайдов: 78

Холера Эшерихиозы Дизентерия Листериоз КАФЕДРА МИКРОБИОЛОГИИ И ВИРУСОЛОГИИ РНИМУ ИМ. Н. И. ПИРОГОВА

Холера Cholera Это острая антропонозная кишечная инфекция, которая характеризуется • водной диареей (watery diarrhea) • нарушением водно-солевого обмена • обезвоживанием (dehydratation), • что проявляется в форме энтерита или гастроэнтерита и нарушения сердечнососудистой системы

Холера отнесена к группе особо опасных карантийных заболеваний Исторический очерк • холера известна с древних времен, первые упоминания в санскритских ведах -500 лет до н. э. • До XIX века холера встречалась только в Индии, в долинах рек Ганга и Брахмапутры, где образовались эндемические очаги.

Исторический очерк • В начале XIX века холера заносится в Европу, В Россию – через Астрахань и Оренбург. Впервые вибрион описал Ф. Пачини (Флоренция). Этиологическую роль вибриона доказал Р. Кох (1883 г. ) – он выделил чистую культуру вибриона в Египте и позже – в Индии. В 1937 -1938 г. г. Появился новый эндемик в Индонезии – на острове Сулавеси

Исторический очерк (продолжение) Возбудитель отличался от классического варианта, ранее этот вибрион был описан на карантинной станции Эль -Тор в Египте. С 1961 года началась 7 -я пандемия холеры, обусловленная именно этим вибрионом, получившим название Эль -Тор. К началу XXI века пандемия охватила около 100 стран мира. В последующие годы регистрировали случаи холеры (вариант Эль -Тор) в России (Астрахань) и сопредельных государствах - на Украине (Одесса, Керчь), в Казахстане, Узбекистане

Этиология Возбудитель холеры Vibrio cholerae представлен двумя биологическими вариантами: Vibrio cholerae, биовар классический Vibrio cholerae, биовар El. Tor. Это Грам - палочки, аэробы, имеют жгутики

Отличия биовара Эль-Тор от класического биовара Vibrio cholerae Эль-Тор: • устойчив во внешней среде и быстро распространяется по регионам мира • вызывает бессимптомную инфекцию • лизис эритроцитов животных в течение 48 ч

Общие свойства биоваров возбудителя холеры Морфология: • изогнутые палочки, • Грам-, • в капле жидкостивыстраиваются как «стая рыб» .

Общие свойства биоваров возбудителя холеры • Культуральные свойства – образование пленки на жидких средах

Общие свойства биоваров возбудителя холеры • Культуральные свойства –рост на среде с желатином • Биохимическое типирование: разлагают крахмал, • разжижают желатину, • Нe разлагают арабинозу ara-
Общие свойства биоваров возбудителя холеры (фаготипирование, тест на чувствительность к антибиотикам

Общие свойства биоваров возбудителя холеры • Серологическое типирование: серогруппа 01, которая включает • 3 серотипа. Инаба, Огава, Гикошима. Исключение: вибрион 0: 139 Бенгал, способный продуцировать токсин Реакция агглютинации на стекле

Бактериологическое исследование • Питательные среды: • Жидкая I% щелочная пептонная вода • Плотные среды: щелочной агар, TCBS (желтые колонии на зеленом фоне) • Для сокращения сроков культивирования получают “пленку” из вибрионов в жидкой питательной среде, а затем делают посев на плотные среды
Колонии Vibrio cholerae (среда. TCBS)

Эпидемиология Источник инфекции • больные типичной формой холеры, • больные субклинической формой • • • (выделители) находящиеся в инкубационном периоде реконвалесценты (продолжающие выделять вибрионы в течение 2 -4 нед. ) здоровые (транзиторные) носители, переодически выделяющие (9 -14 дней) вибрионы

Основные пути передачи инфекции • Водный (Эль-Тор сохраняется у обитателей водоемов, включая рыбы, крабы, креветки, моллюски) • Пищевой(сохраняется в холодильнике на сыром мясе, рыбе, овощах и фруктах), • Контактный • Трансмиссивный (может также переноситься с мухами)


Свойства • Vibrio cholerae сохраняются при комнатной температуре и в холодильнике • погибают при кипячении через 1 мин или при нагревании до 56 С через 30 мин • чувствительны к действию желудочного сока, УФ • чувствительны к хлорсодержащим препаратам, сулеме

Патогенный микроорганизм V. cholerae

ФАКТОРЫ ПАТОГЕННОСТИ Факторы адгезии и колонизации • Протеазы - ферменты, осуществляют гидролиз слизи для подхода вибриона к поверхности энтероцитов • Токсин-корегулирующие пили (Tcp A); их адгезивный эффект служит механизмом запуска продукции токсина (активность пилей и синтез холерогена кодирует одна и та же система регуляторных генов) • Адгезины - белки на концах пилей (способствуют адгезии и колонизации),

Факторы патогенности • Фактор проницаемости -нейраминидаза, действует в комплексе с толерогеном и способствует проникновению токсина в клетку • Экзотоксин (толероген, белковый токсин) действует как энтеротоксин и вызывает основные проявления холеры обезвоживание и нарушение водносолевого обмена, • Эндотоксин (липополисахарид, ЛПС) вызывает интоксикацию, поликлональную пролиферацию В клеток -

Экзотоксин холерного вибриона Структура и взаимодействие с клеткой Токсин состоит из 2 -х субъеднниц A и B: A- субъединица (2 компонента А 1 и А 2), ответственна за токсические свойства, B- субъединица (5 компонентов), ответственна за связывание на энтероцитах и иммуногенность. При взаимодействии с клеткой Всубъединица связывается с GM 1 ганглиозидными рецепторами энтероцитов и встраивается в клеточную мембрану, при этом дисульфидные мостики разрываются


МЕХАНИЗМ ДЕЙСТВИЯ ХОЛЕРНОГО ТОКСИНА Токсин не вызывает повреждения клеток, его механизм действия связан с повышением концентрации ц. АМФ путем воздействия на встроенную в клеточную мембрану аденилатциклазную систему

Функция аденилатциклазной системы - регуляция потребления и выхода жидкости через мембрану • Система состоит из G-белка и циклазы. • G-белок - способен выполнять функцию GTPазы (расщеплять GTP до GDP) • В норме возможны 2 состояния G-белка 1. G+GTP c усилением активности циклазы и повышением синтеза ц. АМФ, что приводит к выходу жидкости из энтероцитов 2. G+ GDP (результат расщепления GTP до GDP), что приводит к неактивной форме циклазы, снижению синтеза ц. АМФ и потреблению растворимых веществ

Воздействия холерного токсина на Gsα-субъединицу G-белка (механизм диареи) • Токсин обладает активностью ADPрибозил-трансферазы и катализирует перенос ADP-рибозил группы с фермента NAD на GTP-связывающий белок (Gsαсубъединицу G-белка - мишень ); В результате - • происходит ADP-рибозилирование Gsα и отмена фазы G+GDP • комплекс G-белок+GTP приводит к постоян ной активации аденилатциклазы и повыше нию внутриклеточного синтеза ц. АМФ. • Жидкость выходит в просвет кишечника

патогенез холеры (4 звена) • 1 - вибрион проникает через рот, поступает в желудок, где может погибнуть от кислоты желудочного сока или при сниженной кислотности следует в тонкую кишку; • 2 - в тонкой кишке высокое содержание пептона и благоприятная щелочная среда; здесь происходит интенсивное размножение вибрионов, которые располагаются на поверхности слизистой оболочки и в просвете тонкой кишки.

ПАТОГЕНЕЗ ХОЛЕРЫ (продолжение) • 3 -размножение вибрионов приводит к накоплению эндотоксина, а при адгезии через Tc. P(токсин-корегулирующие пили) происходит запуск продукции экзотоксина. • Экзотоксин проникает в энтероциты, активирует аденилатциклазную систему путем воздействия на G-белок, что приводит к повышению концентрации ц. АМФ и усилению секреции воды и электролитов.

ПАТОГЕНЕЗ ХОЛЕРЫ (продолжение) • 4 - происходит быстрая утрата крупных объемов жидкости и развитие диареи (электролитной). • Степень и скорость обезвоживания и деминерализации определяют тяжесть течения холеры. • Возможен шок как результат снижения объема циркулирующей крови (hypovolemia)


Патогенез холеры Утрата воды и электролитов приводит к обезвоживанию организма: • Падает артериальное давление • Нарушается микроциркуляция • Развивается гипоксия тканей • Метаболический ацидоз • Гипокалиемия • Острая почечная недостаточность • Сердечная недостаточность • Возможен гиповолемический шок

Принципы лабораторной диагностики Методы: 1. Бактериологический – основной метод 2. Серологический – определение антител к холерогену, агглютинины и вибриоцины в сыворотке – РПГА, ИФА 3. Молекулярно-генетический (ПЦР для определения генов, ответственных за активность факторов вирулентности) 4. Ускоренные методы диагностики (прямая иммунофлюоресценция, антитела анти-О к 1 Аг)

Подходы к лечению • • • регидратация (препараты: трисоль, квартасоль; оралит ( рекомендован ВОЗ), купирование интоксикации (нитрофураны, фторхинолоны), связывание и выведение токсина (ваулен, энтеродез), применение цитопротекторов (смекта), восстановление нормальной микрофлоры

ПОДХОДЫ К ПРОФИЛАКТИКЕ • Полученная вакцина первого поколения (живая аттенуированная) оказалась не вполне эффективна. • К успеху может привести вакцина, которая способна формировать антибактериальный, антитоксический и местный иммунитет.

Эшерихиозы § Это заболевания, вызываемые патогенными штаммами Escherichia coli § Их отличия от условно-патогенной кишечной палочки - в продукции факторов патогенности, ответственных за клиническую картину заболевания. § Их сходство с условно-патогенной E. coli по основным морфологическим, биохимическим, культуральным cвойствам

Микробиологическая идентификация E. coli Возбудители эшерихиозов сохраняют классические характеристики E. coli: • грамотрицательные палочки, • образуют лактозоположительные (Lac+, яркокрасные с металлическим блеском) колонии на средах Эндо и Левина, • ферментируют глюкозу (с образованием газа), лактозу, сахарозу (вариабельно), маннит

Escherichia coli Грам. Lac+
Эшерихиозы (Lac+ колонии)

E. Coli - иммунофлюоресценция

Категории эшерихиозов • 1 - ETEC энтеротоксигенная E. coli, штаммы O 6, O 7, O 8, O 9, O 148, O 158. Клиника -холероподобный синдром (диарея путешественников), инкуб. период - 16 -72 ч, болеют взрослые и дети. Факторы патогенности: LT -термолабильный токсин, ST-термостабильный токсин (или оба), их синтез кодируют гены плазмид, структура LT подобна В-субъединице толерогена

Энтеротоксигенная E. coli

2 категория эшерихиозов • § 2 -EPEC энтеропатогенная E. coli Открыл Эшерих, 1886. Штаммы O 26, O 55, O 125, O 44. Клиника- водная диарея, эксикоз у детей до 1 года жизни, инкуб. период 6 -24 ч. Факторы патогенности: связанные в узел пили, которые через сигнальную систему вызывают фосфорилирование белка Hp-90 клеток эпителия, активацию фосфолипазы С. Повреждающее действие связано с перестройкой цитоскелетной структуры. Энтеротоксина не выявлено.

3 категория эшерихиозов • § 3 - EIEC энтероинвазивная E. coli штаммы O 124, O 135, O 143, O 144 клиника- дизентерия-подобный синдром, локализация процесса- нижний отдел подвздошной кишки, толстая кишка. Чаще болеют дети 1, 5 -2 лет, подростки. Инкуб. период 6 -48 ч. Факторы патогенности: плазмида, подобная плазмиде шигелл, кодирующая токсигенные, инвазивные свойства. EIEC внедряется и размножается в клетках слизистой оболочки кишки, вызывая ее деструкцию.

4 категория эшерихиозов • § 4 -EHEC энтерогеморрагическая E. coli Штамм O 157: H 7 госпитальный. Вспышки в домах престарелых. Инкуб. период 72 -120 ч. Клиника- геморрагический колит, тромбоцитопеническая пурпура, диарея, гемолитический-уремический синдром. Факторы патогенности: фактор адгезии - плазмида кодирует новый тип фимбрий; синтез 2 -х токсинов, один из которых подобен токсину типа 1 шигелл (шигеллоподобный токсин)

Энтерогеморрагическая E. coli Обнаружена у человека и крупного рогатого скота. • EHEC может вызывать гемолитический уремический синдром и острую почечную недостаточность. •

5 категория эшерихиозов EAgg. EC энтероагрегативная E. coli Аутоагглютинаты (агрегаты) в культуре ткани ассоциируются с диареей детей раннего возраста (до 6 мес) Наряду с этим, выявлена персистирующая диарея у ВИЧинфицированных взрослых лиц

Энтероагрегативная E. coli • Бактерии обнаружены только у человека, • получили свое название за способность с помощью фимбрий вызывать агрегацию клеток в клеточной культуре • EAgg. EC адгезируют на поверхности слизистой тонкого кишечника и вызывают водную диаррею без лихорадки • Неинвазивны, продуцируют гемолизин и ST-энтеротоксин, сходный с энтеротоксином энтеротоксигенных эшерихий

Escherichia coli

Дизентерия • Это инфекционное заболевание, вызванное бактериями рода шигелл, которое характеризуется • интоксикацией и • поражением дистального отдела толстого кишечника (слизь, кровь в стуле), часто с хроническим течением (У детей нередко поражается и подвздошная кишка) Изучение заболевания связано с именами Шига, Григорьева, Штуцера, Шмитца, Ларджа, Сакса, Флекснера, Бойда, Зонне

Shigella – возбудитель дизентерии • Семейство Enterobacteriaceae • Род Shigella Дизентерия - полиэтиологическое заболевание Shigella dysenteriae, S. flexneri, S. boydii, and S. sonnei • Виды:


Shigella морфология • Мелкие грамотрицательные палочки с закругленными концами, неподвижные S. sonnei - ферментируют лакатозу

Shigella Трансмиссивная электронная микроскопия. Колонизация эпителиоцитов Шигеллы внутри эпителиоцитов
• Факультативные анаэробы • На среде Эндо – бесцветные лактозонегативные колонии • Селективные среды- среда Плоскирева, сальмонеллашигелла агар

• Биохимически малоактивны • расщепляют отдельные углеводы только до кислоты • чувствительны к дезинфектантам Антигены О-антиген - термостабильный, ЛПС наружной мембраны К-антиген – капсульный антиген (поверхностные полисахариды) , термолабильный

Факторы патогенности • Фимбрии и белки наружной мембраны – факторы адгезии, • Ферменты патогенности: гиалуронидаза, муциназа, нейраминидаза, • Эндотоксин (ЛПС); • Токсин Шига и шигаподобные токсины • взаимодействуют с рецепторами энтероцитов, • макрофагов и нервных клеток • обладают цитотоксическим, нейротоксическим и энтеротоксическим эффектами • Шига-токсин может вызывать гемолитический уремический синдром с развитием почечной недостаточности S. flexneri, S. boydii, и S. sonnei способны продуцировать LTэнтеротоксин

ELISA для определения Shiga токсинов в клиническом материале

Shigella после адгезии лизирует мембрану энтероцита и выходит в цитоплазму, вызывает реорганизацию клеточного актина, формируя себе «хвост» , выполняющий роль пропеллера, обеспечивающего перемещение из клетки в клетку. • На рис. А показана иммунофлюоресцетная окраска: клетки шигеллы (красные) перемещаются с помощью полимеризованного актина (зеленый) • На рис. В. Показана реорганизация цитоскелета - полимеризация актина

Shigella flexneri инфицирует культуру клеток Hela Шигеллы -красное свечение и зеленые «хвосты» актина

Патогенез шигеллезов

Лабораторная диагностика • Ускоренные методы - латексагглютинация, прямой метод иммунофлуоресценции • • Бактериологический (культуральный метод) – основной; Серологический метод (ИФА, РСК, РНГА, развернутая реакция агглютинации) для обнаружения антител в сыворотке больного при хронических, атипичных формах и с целью ретроспективной диагностики, Молекулярно-генетический метод: ПЦР

Бактриологический метод Проводят в кратчайшие сроки – «у постели больного» Предварительный этап. Посев в селенитовый бульон 1 этап: Посев клинического материала или пробы из селенитового бульона на среды Эндо, Плоскирева и др. 2 этап: Макро- и микроскопическое изучение колоний пересев лактозонегативных колоний на среды Ресселя или Клиглера. 3 этап: Идентификация : биохимическое тестирование по системе API-20 E; • серологическая (антигенная) идентификация в реакциях агглютинации на стекле (с поливалентной дизентерийной сывороткой и с группоспецифическими сыворотками); • определение чувствительности к антибиотикам

Получение проб биоматериала ( ректальный мазок)

Особенности иммунитета • После перенесенного заболевания формируется типоспецифический иммунитет - к тому виду, с которым связана этиология дизентерии (иммунитет нестойкий) Необходима ранняя и дифференциальная диагностика • S. flexneri (Lac-) от S. sonnei(Lac+ через 48 ч), чтобы разместить больных по разным палатам •

Особенности клинического течения • Инкубационный период 1 -7 дней (чаще 2 -3 дня) • Острое течение –колиты, гастроэнтероколиты, гастроэнтериты, • Хронически рецидивирующее течение Бактериовыделители • Характерные симптомы: • тенезмы (частые позывы), схваткообразные боли, • слизь и кровь – примеси в стуле

Лечение • Симтоматическое: пероральная (в тяжелых случаях внутривенная) регидратация • Патогенетическое: Антибиотики (ампициллин, триметоприм, фторхинолоны, ципрофлоксацин) Дизентерийный поливалентный бактериофаг Профилактика: Инактивированная дизентерийная вакцина (содержит взвесь убитых шигелл) для лечения хронических форм инфекции Препараты для коррекции микрофлоры кишечника

Листериоз

Listeria бактериологический метод

Листерии

Эпидемиология листериоза • Основной источник заболевания для человека – грызуны( домашние мыши и крысы) и сельскохозяйственные животные (обычно животные заражаются через воду и корма, ИНФИЦИРОВАННЫЕ ВЫДЕЛЕНИЯМИ ГРЫЗУНОВ ИЛИ ИХ ТРУПАМИ). Больные животные выделяют листерии с фекалиями и молоком. Пути передачи листериоза - фекально-оральный, трансплацентарный, но возможен контактный, аэрогенный, трансмиссивный. Возможна передача инфекции от больной матери плоду через плаценту или во время родов. • В последние годы листериоз все чаще обнаруживают у наркоманов (выявлены наиболее опасные наркотики, например, фентанил)

Продукты питания – источники листериоза

Пищевые продукты –источник листерий


Факторы патогенности • Это внутриклеточные паразиты • Факторы адгезии и инвазии: фосфолипазы- мембранолитические свойства, лизис макрофагов, интерналины - поверхностные белки, участвуют в инвазии листерий в клетки эпителия, гепатоциты, эндотелия Главный внеклеточный белок –муреингидролаза участвует в адгезии и инвазии Белок Act. A способствует полимеризации актина с образованием «актинового хвоста» для проникновения листерий внутрь клеток. Токсин - листериолизин О (гемолизин)

Клинические проявления • • Первые симптомы появляются через 2 -3 нед после заражения. Больные чувствуют тошноту и рвоту, сонливость, боли в животе. Повышается температура тела до 38 -39 0 Нередко отмечаются признаки поражения ЦНС (энцефалит, менингит). У беременных женщин и детей листериоз сопровождается расстройствами координации, тремором, судорогами и регидностью затылочных мышц Влияние листериоза на развитие плода – бактериемия, поражение печени и селезенки, папулезная сыпь

Листериоз

Лечение и профилактика листериоза • Лечение - не всегда успешно, важно как можно раньше установить диагноз • Наиболее эффективны препараты: ампициллин, гентамицин и бисептол • Используют комплексную терапию: антибактериальную, иммунокорригирующую, симптоматическую • Профилактика -- регулярное проведение санитарногигиенических мероприятий в животноводческих хозяйствах и на предприятиях, которые перерабатывают продукты животного происхождения.

БЛАГОДАРИМ ЗА ВНИМАНИЕ
Холера, эшерихиозы, дизентерия, листериоз.ppt